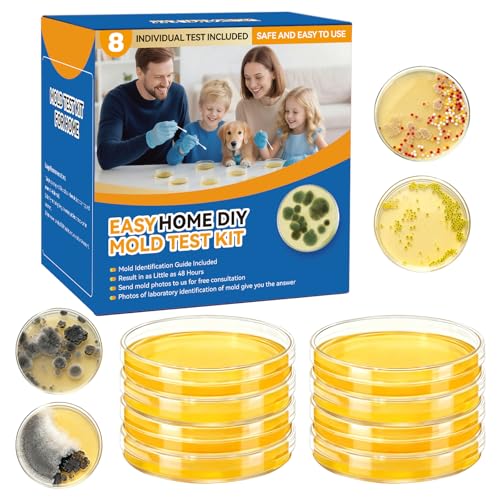
Home Mold Test Kit with Air & Surface Detection

If you’re looking for the 15 best mold risk monitors for your home in 2026, I can help you find top picks that detect mold early, including DIY kits with air, surface, and HVAC testing, as well as smart monitors that integrate with home automation. These tools offer quick results, accurate analysis, and some even include professional lab support. Keep exploring to discover the perfect mold prevention solution for your home environment.
Key Takeaways
- The top mold risk monitors for 2026 feature comprehensive detection methods, including air, surface, and HVAC testing.
- Many offer rapid results, often within 24-72 hours, with options for professional lab analysis and expert support.
- Integration with smart home systems allows real-time monitoring of humidity, temperature, and mold spores for proactive management.
- Cost-effective options include DIY kits and sensors that eliminate the need for costly professional inspections.
- User-friendly design with clear instructions, visual guides, and portable formats make testing accessible for homeowners.
| Mold & Bacteria Test Kit with Detection & Guide |  | Best Overall | Testing Method: Agar slide testing, surface swabs, air samples | Result Time: 24 hours | Identification Support: Species guide, photo consultation | VIEW LATEST PRICE | See Our Full Breakdown |
| Home Mold Test Kit with Air & Surface Detection |  | Best Value | Testing Method: Surface, HVAC, air testing | Result Time: Rapid (within 24 hours) | Identification Support: Mold guide included | VIEW LATEST PRICE | See Our Full Breakdown |
| DIY Mold Test Kit for Home & Air Quality Detection |  | Most Comprehensive | Testing Method: Surface, air, HVAC testing | Result Time: 2-4 days | Identification Support: Mold guide, photo analysis | VIEW LATEST PRICE | See Our Full Breakdown |
| DIY Mold Test Kit with Free Lab Analysis |  | Fastest Results | Testing Method: Plates, swabs, air, surface | Result Time: 48 hours | Identification Support: Mold identification guide, free lab analysis | VIEW LATEST PRICE | See Our Full Breakdown |
| Home Mold Test Kit with Detection & Risk Guide |  | Best All-in-One | Testing Method: Plates, swabs, air, surface | Result Time: Short (within days) | Identification Support: Visual mold guide, photo lab analysis | VIEW LATEST PRICE | See Our Full Breakdown |
| Healthful Home Mold Test with Expert Consultation |  | Easy DIY | Testing Method: Mold test plates, mold detection | Result Time: 48 hours | Identification Support: Mold identification guide, free lab analysis | VIEW LATEST PRICE | See Our Full Breakdown |
| Home Mold Test Kit with Lab Analysis |  | Accurate Detection | Testing Method: Agar plates, sampling, lab analysis | Result Time: 48 hours | Identification Support: Mold guide, lab analysis option | VIEW LATEST PRICE | See Our Full Breakdown |
| Mold Armor Do It Yourself Mold Test Kit |  | Versatile Use | Testing Method: Petri dish, swabs, growth medium | Result Time: 48 hours | Identification Support: Mold growth guide, optional lab analysis | VIEW LATEST PRICE | See Our Full Breakdown |
| Home Mold Test Kit with Rapid Results |  | Rapid Results | Testing Method: Petri plates, air, surface | Result Time: Quick (2-4 days) | Identification Support: Mold guide, photo lab analysis | VIEW LATEST PRICE | See Our Full Breakdown |
| Home Mold Test Kit with 14 Detectors and Guide |  | Bulk Testing | Testing Method: Plates, swabs, air, surface | Result Time: 48–72 hours | Identification Support: Mold guide, free photo lab analysis | VIEW LATEST PRICE | See Our Full Breakdown |
| DIY Mold Test Kit for Indoor Air & Surfaces |  | Multi-Area Coverage | Testing Method: Petri dishes, swabs, surface, air | Result Time: 2-4 days | Identification Support: Mold guide, lab analysis available | VIEW LATEST PRICE | See Our Full Breakdown |
| Home Mold Test Kit for Surfaces & Air Quality |  | Professional Precision | Testing Method: Petri dishes, swabs, multiple surfaces | Result Time: 2-4 days | Identification Support: Mold identification guide, lab analysis | VIEW LATEST PRICE | See Our Full Breakdown |
| Home Mold Test Kit with Air Quality Detection |  | User-Friendly | Testing Method: Plates, swabs, surfaces, air | Result Time: 2-4 days | Identification Support: Mold guide, photo lab analysis | VIEW LATEST PRICE | See Our Full Breakdown |
| Home Mold Test Kit with Air & Surface Detection | | Cost-Effective | Testing Method: Plates, swabs, surfaces, air | Result Time: 48 hours | Identification Support: Mold guide, lab analysis option | VIEW LATEST PRICE | See Our Full Breakdown |
| DIY Mold Test Kit with Air and Surface Detection |  | Extensive Monitoring | Testing Method: Plates, swabs, air, surfaces | Result Time: 2-4 days | Identification Support: Mold guide, free lab analysis | VIEW LATEST PRICE | See Our Full Breakdown |
More Details on Our Top Picks
-

Mold Test Kit for Home Detection: 4 Simple DIY Science Kits for Fastly Testing Home Surfaces & Air Quality Detector & HVAC Monitor Includes Detailed Identification Guide
4 COMPREHENSIVE TESTS FOR A HEALTHY HOME: This home mold test kit tests HVAC systems, home surfaces, and...
As an affiliate, we earn on qualifying purchases.
Mold & Bacteria Test Kit with Detection & Guide
If you’re looking for an easy and reliable way to detect mold and bacteria in your home, the Mold & Bacteria Test Kit with Detection & Guide is an excellent choice. It’s designed for DIY use, letting you test indoor air, surfaces, and HVAC systems quickly and easily. The kit includes everything you need—test slides, swabs, vent clips, and detailed instructions—so you can get accurate results without sending samples to a lab. Results appear within 24 hours, and it covers multiple locations, from walls to vents. Plus, with free expert support and a thorough species guide, it’s a practical tool for maintaining a healthier indoor environment.
- Testing Method:Agar slide testing, surface swabs, air samples
- Result Time:24 hours
- Identification Support:Species guide, photo consultation
- Testing Locations:Indoor air, surfaces, HVAC
- Sample Types:Agar slides, swabs, air samples
- Material:Agar, sterile slides
- Additional Feature:USA manufactured quality
- Additional Feature:Species identification guide
- Additional Feature:Free photo consultation
-

Mold Test Kit for Home,7 Simple Detection Tests,Test HVAC System,Home Surfaces, Indoor Air Quality Testing,DIY Mold Detector for Home,Includes Detailed Mold Identification Guide,Black Mold Testing kit
7 Complete Mold Testing Kit - This DIY home mold test kit includes 7 individual tests, allowing you...
As an affiliate, we earn on qualifying purchases.
Home Mold Test Kit with Air & Surface Detection
A home mold test kit with air and surface detection is the perfect choice for anyone wanting a thorough, do-it-yourself assessment of their indoor environment. It includes four tests that evaluate HVAC systems, surfaces, and air quality, giving a complete view of potential mold issues. The kit features professional-grade tools and a clear identification guide, making it easy to use without expertise. Results are fast and reliable, helping you understand mold types and respond promptly. Suitable for homes, offices, or schools, it’s an affordable way to protect health with professional-grade accuracy and simple, effective testing at your convenience.
- Testing Method:Surface, HVAC, air testing
- Result Time:Rapid (within 24 hours)
- Identification Support:Mold guide included
- Testing Locations:HVAC, surfaces, air
- Sample Types:Surface, air, HVAC samples
- Material:Testing media, tools
- Additional Feature:Professional-grade testing tools
- Additional Feature:Clear mold identification guide
- Additional Feature:Cost-effective testing solution
-

Mold Test Kit for Home -DIY Mold Testing Kit with 6 Individual Tests-Black Mold Detector-Indoor Air Quality Tester-Mold Identification Guide-Free Lab Analysis-Fast and Reliable Mold Detector at Home
Complete Test Kit :6 test plates,allowing you to conduct thorough and extensive mold assessments throughout your home,swabs,sealed bag,...
As an affiliate, we earn on qualifying purchases.
DIY Mold Test Kit for Home & Air Quality Detection
The DIY Mold Test Kit for Home & Air Quality Detection is an excellent choice for homeowners who want an affordable, all-encompassing way to monitor mold risks without professional help. It offers seven detection tests, covering surfaces, HVAC systems, and indoor air quality. I appreciate its three testing methods—air, surface, and HVAC—allowing thorough assessments across multiple areas. Results come back within 2-4 days, so I can take prompt action if needed. The kit includes a detailed identification guide and free lab analysis for accuracy. Its compact design makes it easy to use at home, providing reliable insights into mold presence and helping me maintain a safer environment.
- Testing Method:Surface, air, HVAC testing
- Result Time:2-4 days
- Identification Support:Mold guide, photo analysis
- Testing Locations:Surfaces, HVAC, air
- Sample Types:Surface, air, HVAC samples
- Material:Agar plates, swabs
- Additional Feature:Compact, portable design
- Additional Feature:Laboratory analysis option
- Additional Feature:Top-ranked in indoor air quality
DIY Mold Test Kit with Free Lab Analysis
Homeowners seeking a thorough and affordable way to assess mold risks will find the DIY Mold Test Kit with Free Lab Analysis to be an ideal choice. This kit includes six test plates, swabs, gloves, and a mold identification guide, enabling detailed testing of various home areas like rooms, HVAC systems, attics, and basements. You can send photos of mold for free lab analysis to identify toxic molds such as black mold. Results come back within 48 hours, providing a clear picture of mold distribution throughout your home. It’s easy to use, safe, and eliminates costly lab fees, making it a smart, budget-friendly solution for DIY mold detection.
- Testing Method:Plates, swabs, air, surface
- Result Time:48 hours
- Identification Support:Mold identification guide, free lab analysis
- Testing Locations:Multiple household areas
- Sample Types:Plates, swabs, air, surface
- Material:Agar plates, swabs
- Additional Feature:48-hour rapid results
- Additional Feature:Broad coverage areas
- Additional Feature:Easy-to-use test plates
Home Mold Test Kit with Detection & Risk Guide
If you want an easy way to monitor mold risks without professional help, the Home Mold Test Kit with Detection & Risk Guide is an excellent choice. It’s a complete 6-in-1 kit that includes test plates, swabs, gloves, labels, and a detailed identification guide, making DIY assessment straightforward. The kit uses three sampling methods—air, surfaces, and HVAC—giving a thorough view of mold presence throughout your home. With rapid visual identification and clear instructions, you can quickly recognize common molds and assess risks. It’s a cost-effective, safe solution perfect for proactive homeowners aiming to detect mold early and maintain a healthier environment.
- Testing Method:Plates, swabs, air, surface
- Result Time:Short (within days)
- Identification Support:Visual mold guide, photo lab analysis
- Testing Locations:Surfaces, HVAC, air
- Sample Types:Plates, swabs, air, surface
- Material:Agar plates, swabs
- Additional Feature:Visual mold guide included
- Additional Feature:Multi-method home testing
- Additional Feature:Affordable DIY solution
Healthful Home Mold Test with Expert Consultation
Anyone concerned about hidden mold issues will find the Healthful Home Mold Test with Expert Consultation especially valuable, as it quickly detects dangerous mold types without the need for lab visits or waiting days for results. This test uses patented U.S. PHS technology to identify harmful molds like Aspergillus, Penicillium, and Stachybotrys, focusing solely on unhealthy spores. It’s simple to use—just three steps—and works even if mold isn’t visible. Plus, the included expert consultation helps ensure accurate interpretation and guidance. As seen on the Today Show, this test combines safety, reliability, and convenience, making it an excellent choice for proactive mold detection at home.
- Testing Method:Mold test plates, mold detection
- Result Time:48 hours
- Identification Support:Mold identification guide, free lab analysis
- Testing Locations:Indoor surfaces, air
- Sample Types:Plates, mold detection
- Material:Plastic plates
- Additional Feature:Detects specific harmful molds
- Additional Feature:Trusted on the Today Show
- Additional Feature:No lab visits needed
Home Mold Test Kit with Lab Analysis
The Home Mold Test Kit with Lab Analysis is an ideal choice for those seeking a straightforward, reliable method to detect mold in their living spaces. It allows quick testing of indoor air, surfaces, and HVAC systems, helping you identify mold types that can cause health issues. The kit includes four AGAR plates, detailed identification guides, swabs, and gloves for safe testing. Plates are vacuum-packed and remain fresh for up to two months. If you’re unsure about your results, you can send photos to the lab for expert analysis within 24 hours. This kit simplifies mold detection and supports prompt, effective remediation.
- Testing Method:Agar plates, sampling, lab analysis
- Result Time:48 hours
- Identification Support:Mold guide, lab analysis option
- Testing Locations:Multiple household surfaces, air
- Sample Types:Agar plates, samples
- Material:Agar plates, sampling tools
- Additional Feature:Multiple sample areas
- Additional Feature:Includes mold removal instructions
- Additional Feature:Professional lab analysis available
Mold Armor Do It Yourself Mold Test Kit
The Mold Armor Do It Yourself Mold Test Kit stands out as an easy and reliable option for homeowners concerned about hidden mold issues. It delivers visible results within 48 hours, making it a quick way to assess both indoor and outdoor environments. The kit offers three testing methods: indoor air quality, HVAC samples, and surface testing when mold is visible. It includes all necessary components—petri dish, swab, and growth medium—so no extra tools are needed. For more precise identification, you can send samples to certified microbiologists. Plus, the Mold Blocker spray helps prevent future mold growth, offering ongoing protection.
- Testing Method:Petri dish, swabs, growth medium
- Result Time:48 hours
- Identification Support:Mold growth guide, optional lab analysis
- Testing Locations:Indoor surfaces, air
- Sample Types:Petri dishes, swabs
- Material:Petri dishes, swabs
- Additional Feature:Indoor and outdoor testing
- Additional Feature:Optional lab analysis
- Additional Feature:Mold growth prevention spray
Home Mold Test Kit with Rapid Results
Looking for a fast and reliable way to detect mold in your home? The Home Mold Test Kit with Rapid Results offers thorough testing with eight assessments covering HVAC systems, surfaces, and indoor air quality. It’s designed for easy DIY use, including professional-grade tools, clear instructions, and an identification guide to help you understand mold types. Results come quickly, enabling you to make prompt decisions. Perfect for homeowners, renters, or property managers, it provides affordable, professional-level accuracy without the need for experts. This kit ensures you can maintain a healthy indoor environment efficiently and effectively.
- Testing Method:Petri plates, air, surface
- Result Time:Quick (2-4 days)
- Identification Support:Mold guide, photo lab analysis
- Testing Locations:HVAC, surfaces, air
- Sample Types:Petri plates, air, surface
- Material:Petri dishes, growth medium
- Additional Feature:Fast, 2-4 day results
- Additional Feature:Clear mold identification
- Additional Feature:User-friendly testing process
Home Mold Test Kit with 14 Detectors and Guide
If you’re concerned about hidden mold lurking in your home or workspace, this Home Mold Test Kit with 14 detectors is an ideal solution. It quickly identifies potential mold hotspots in walls, HVAC systems, furniture, and air quality within 48–72 hours. The kit includes 14 sterile test plates, swabs, gloves, and a detailed guide, making it easy for beginners to use. It offers lab-quality accuracy at a fraction of professional costs. Plus, you can email photos for free expert analysis, ensuring reliable results and tailored mold prevention advice. Early detection helps keep your environment healthy and avoids costly repairs.
- Testing Method:Plates, swabs, air, surface
- Result Time:48–72 hours
- Identification Support:Mold guide, free photo lab analysis
- Testing Locations:Multiple indoor areas
- Sample Types:Plates, swabs, air, surface
- Material:Plates, swabs
- Additional Feature:14 test plates included
- Additional Feature:Professional interpretation support
- Additional Feature:Detects multiple mold types
DIY Mold Test Kit for Indoor Air & Surfaces
A DIY mold test kit is ideal for homeowners who want a quick, affordable way to assess indoor air quality and surface contamination without waiting for professional inspections. This complete kit includes six petri dishes, a detailed mold identification guide, cotton swabs, label stickers, and protective gloves, making testing safe and straightforward. It works on various surfaces and environments, from bedrooms to basements and even vehicles. You can test multiple areas simultaneously, detect different mold types, and identify potential hazards like black mold. Best of all, it’s cost-effective, eliminates lab fees, and provides easy-to-follow instructions, giving you peace of mind in just a few simple steps.
- Testing Method:Petri dishes, swabs, surface, air
- Result Time:2-4 days
- Identification Support:Mold guide, lab analysis available
- Testing Locations:Surfaces, air, HVAC
- Sample Types:Petri dishes, swabs
- Material:Petri dishes, swabs
- Additional Feature:Multiple testing locations
- Additional Feature:Simple 3-step process
- Additional Feature:Safe, easy operation
Home Mold Test Kit for Surfaces & Air Quality
Homeowners and property managers seeking thorough mold detection will find the Home Mold Test Kit for Surfaces & Air Quality to be an excellent choice. It offers 12 scientific tests that cover HVAC systems, home surfaces, and indoor air, giving a complete picture of your environment. The kit is designed for easy use, with professional-grade tools, accessories, and clear instructions—no expertise needed. Results are fast and reliable, helping you identify mold types quickly. Its versatility makes it suitable for homes, offices, schools, and rentals. Plus, it provides professional-quality insights at an affordable price, making mold monitoring accessible for everyone.
- Testing Method:Petri dishes, swabs, multiple surfaces
- Result Time:2-4 days
- Identification Support:Mold identification guide, lab analysis
- Testing Locations:Surfaces, air, HVAC
- Sample Types:Petri dishes, swabs
- Material:Petri dishes, swabs
- Additional Feature:12 comprehensive tests
- Additional Feature:Suitable for various environments
- Additional Feature:Cost-effective professional quality
Home Mold Test Kit with Air Quality Detection
The Home Mold Test Kit with Air Quality Detection is an excellent choice for anyone wanting a complete, DIY solution to monitor indoor mold and air quality. It includes six test plates, swabs, gloves, and a detailed identification guide, making it easy to test various surfaces, air, HVAC systems, and even cars. You can sample multiple locations, compare results with helpful images, and send pictures for expert help if needed. The kit also provides clear removal instructions to eliminate mold safely. Designed for safety and simplicity, it helps homeowners maintain healthier indoor environments without professional assistance.
- Testing Method:Plates, swabs, surfaces, air
- Result Time:2-4 days
- Identification Support:Mold guide, photo lab analysis
- Testing Locations:Walls, furniture, HVAC, air
- Sample Types:Plates, swabs, surfaces
- Material:Plates, swabs
- Additional Feature:Multiple sampling sites
- Additional Feature:Includes mold removal guide
- Additional Feature:Safe for DIY use
Home Mold Test Kit with Air & Surface Detection
If you’re looking for a reliable way to detect mold in your living space, the Home Mold Test Kit with Air & Surface Detection is an excellent choice. It includes 8 tests, cotton swabs, label stickers, and gloves for thorough assessments across various surfaces and air environments. You can use it on walls, showers, sinks, and even in your car. The kit employs three testing methods—air samples, HVAC testing, and surface swabs—delivering results in just 2-4 days. It’s easy and safe to use, making it perfect for homeowners, renters, and property managers who want quick, accurate mold detection without lab fees.
- Testing Method:Plates, swabs, surfaces, air
- Result Time:48 hours
- Identification Support:Mold guide, lab analysis option
- Testing Locations:Surfaces, air, HVAC
- Sample Types:Plates, swabs, surfaces
- Material:Plates, swabs
- Additional Feature:8 tests included
- Additional Feature:Quick, 2-4 day results
- Additional Feature:Suitable for multiple surfaces
DIY Mold Test Kit with Air and Surface Detection
Anyone looking for an easy, reliable way to detect mold in their living space will find this DIY Mold Test Kit with Air and Surface Detection to be an excellent choice. It offers 14 tests to evaluate indoor air, surfaces, and HVAC systems, helping identify household molds, including black mold. The kit uses three testing methods, covering walls, showers, sinks, and even car interiors, with results in just 2-4 days. It includes a detailed mold guide and access to free lab analysis by submitting photos. Compact and straightforward to use, this kit empowers you to monitor indoor air quality and address mold issues promptly.
- Testing Method:Plates, swabs, air, surfaces
- Result Time:2-4 days
- Identification Support:Mold guide, free lab analysis
- Testing Locations:Walls, furniture, HVAC, air
- Sample Types:Plates, swabs, air, surfaces
- Material:Plates, swabs
- Additional Feature:14 detection tests
- Additional Feature:Free lab analysis option
- Additional Feature:Compact, lightweight design
Factors to Consider When Choosing a Mold Risk Monitor for Home

When choosing a mold risk monitor for my home, I consider how accurate and wide its detection range is to guarantee reliable results. I also look for devices that are easy to use and provide quick feedback, so I don’t have to wait long for answers. Ultimately, I weigh the cost, maintenance needs, and extra features like data monitoring to find the best fit for my needs.
Detection Accuracy and Range
Choosing a mold risk monitor for your home hinges on its detection accuracy and range. I look for devices with high sensitivity to catch low mold spore levels, which helps identify issues early. It’s important that the monitor covers a broad detection range, including common indoor molds like black mold (Stachybotrys) and allergenic molds such as Aspergillus and Penicillium. I also check if it can sample air, surfaces, and HVAC systems for a thorough assessment. The detection limit should be capable of identifying mold concentrations relevant to health risks. Adjustable sensitivity settings are a plus, allowing me to tailor monitoring based on specific environments. Overall, a reliable monitor with precise detection ensures I can maintain a safe, mold-free home.
Ease of Use
A mold risk monitor that’s easy to use can make all the difference in maintaining a healthy home environment. I look for devices with clear, step-by-step instructions that simplify testing, even if I have no technical background. The best monitors feature straightforward operation, with minimal setup, simple sample collection, and easy-to-read results through visual charts or digital screens. Quick results—preferably within minutes to a few hours—are essential, saving me time and effort. I also appreciate intuitive controls and clear labels that boost confidence during testing. Automated features or guided prompts are especially helpful, ensuring I interpret results correctly and know the next steps without guesswork. Overall, an easy-to-use monitor makes testing less intimidating and more accessible for everyone.
Speed of Results
How quickly a mold risk monitor provides results can substantially impact how effectively I can address potential mold issues in my home. Fast results mean I can detect mold presence in just minutes or hours, rather than waiting days for lab analysis. This immediate feedback allows me to take prompt action, reducing exposure risks and preventing mold from spreading. Devices that use real-time sensors or visual indicators typically deliver faster results, making them ideal for urgent health concerns or routine checks. The speed of results also influences how often I test—quicker devices encourage more regular monitoring. When choosing a mold risk monitor, I consider this factor essential, ensuring I can respond swiftly to any mold threats and maintain a healthier living environment.
Data Monitoring Features
Effective mold risk monitoring relies on data features that provide clear, actionable insights. I look for monitors that track mold spores, humidity, and temperature in real time, so I can spot potential issues early. A thorough dashboard with visual graphs and historical data helps me analyze trends over days or weeks. Alerts or notifications, like alarms or app alerts, are essential—they notify me immediately if mold risk levels go beyond safe limits. Compatibility with smart home systems or mobile apps is a big plus, allowing me to monitor remotely and manage data easily. Accurate data logging with timestamps helps me track patterns over time, supporting effective remediation efforts. These features ensure I stay informed and proactive about my home’s mold risks.
Cost and Maintenance
When choosing a mold risk monitor for my home, I need to think about not only the initial purchase price but also the ongoing maintenance costs that can add up over time. I consider whether the device requires frequent replacement parts or consumables, which can increase long-term expenses. I also check if it uses rechargeable batteries or disposable ones, as this impacts daily or monthly costs. Calibration or professional servicing can add to the maintenance budget, so I want a device that’s easy to calibrate or requires minimal upkeep. Additionally, I evaluate the availability and affordability of replacement sensors or components, ensuring I can keep the monitor functioning effectively without breaking the bank. These factors help me choose a device that’s cost-effective over the years.
Compatibility and Integration
Choosing a mold risk monitor isn’t just about accuracy and cost; it’s also about how well it works with my existing smart home setup. I need to guarantee the device supports wireless options like Wi-Fi or Bluetooth so I can receive alerts remotely. Compatibility with my smartphone’s operating system, whether iOS or Android, is vital for easy access. I also look for integration with other environmental sensors, such as humidity or temperature detectors, to get a thorough view of indoor air quality. Additionally, compatibility with my home automation platform allows me to automate responses, like activating air purifiers when mold risk is high. Seamless integration ensures I can monitor and manage mold risks effortlessly, making my smart home smarter and safer.
Frequently Asked Questions
How Accurate Are Home Mold Risk Monitors Compared to Professional Inspections?
Home mold risk monitors are helpful, but they don’t match the accuracy of professional inspections. I’ve found them useful for early detection and monitoring, yet they can sometimes give false positives or miss hidden mold. For the most reliable results, I recommend combining monitor readings with a certified mold inspector’s assessment. That way, you guarantee your home’s safety and address any hidden issues effectively.
What Is the Typical Lifespan of a Mold Risk Monitor Device?
A mold risk monitor typically lasts around 2 to 3 years before needing replacement or calibration. I’ve found that maintaining and regularly checking these devices helps guarantee accurate readings over time. Factors like usage frequency, environmental conditions, and device quality can influence lifespan. If you notice inconsistent results, it’s a good idea to replace or recalibrate your monitor to keep your home safe and healthy.
Can Mold Risk Monitors Detect All Types of Mold Species?
Think of mold risk monitors as vigilant guardians, but even they can’t catch every mold species lurking in the shadows. While they detect common molds and measure overall humidity and airborne spores, some rare or hidden molds may slip past their sensors. So, I’d say they’re excellent for general monitoring, but for complete assurance, a professional inspection remains the best way to identify all mold types in your home.
How Often Should a Mold Risk Monitor Be Calibrated or Maintained?
I recommend calibrating your mold risk monitor at least once every six months to make certain accuracy. Regular maintenance, like cleaning sensors and checking connections, helps prevent false readings. If you notice inconsistent data or sudden changes, it’s wise to calibrate sooner. Always follow the manufacturer’s guidelines for specific calibration intervals and procedures. Staying proactive with maintenance keeps your monitor reliable and helps protect your home from mold issues.
Are There Specific Features That Indicate a Monitor’s Suitability for Sensitive Environments?
When choosing a mold risk monitor for sensitive environments, I look for features that whisper reliability. A monitor with high accuracy, fast response times, and stable calibration is essential. I also prefer models with adjustable alerts and data logging, so I can stay ahead without surprises. These features guarantee peace of mind, helping me maintain a healthy space without constant worry, making the environment safer and more comfortable.
Conclusion
Did you know that mold can begin growing within 24-48 hours of moisture exposure? That’s why having a reliable mold risk monitor is essential for keeping your home safe. With the right kit, you can detect hidden mold early and prevent health issues. Investing in one of these top monitors in 2026 could save you time, money, and a lot of stress. Don’t wait—protect your home and loved ones today!









